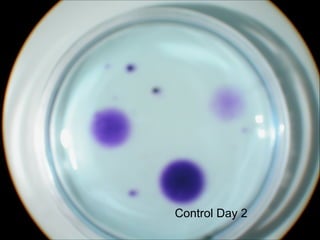
Control Day 2
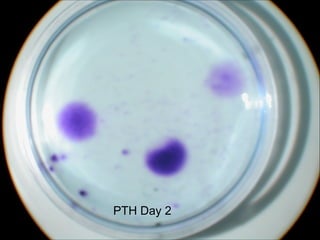
PTH Day 2
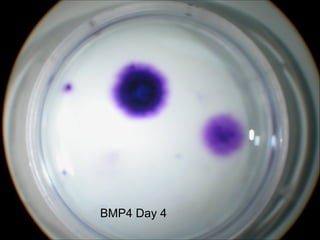
BMP4 Day 4

The document examines the effects of BMP-4, FGF-2, and PTH on chondrogenesis using micromass cultures of chick limb bud cells. The experiment found that BMP-4 and FGF-2 increased cartilage nodule formation over time, with BMP-4 showing the most nodules. PTH also increased nodules but to a lesser extent than BMP-4 and FGF-2. The growth factors promote chondrogenesis by regulating processes like cell proliferation, differentiation and matrix synthesis during endochondral ossification.